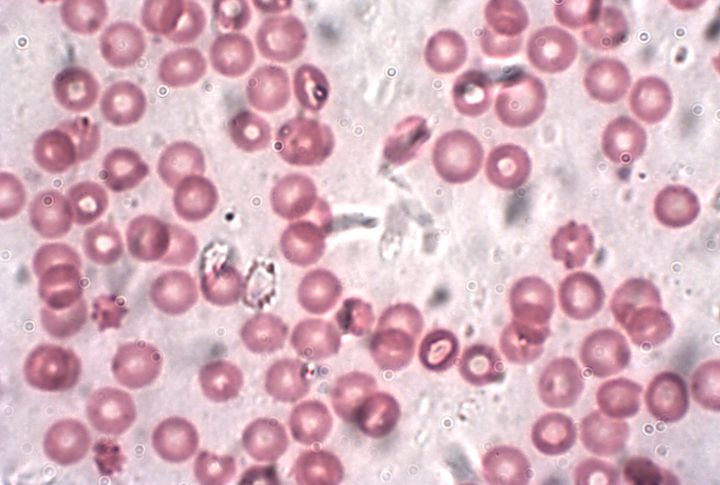

Religious texts weren’t written as science journals. Yet archaeologists and researchers keep unearthing evidence that lines up with biblical narratives in ways nobody expected. We’re talking specific, documented discoveries that made scholars do a double-take. Here are 20 times modern science basically said, “Huh, that checks out.”
The Universe Had A Beginning

The Bible starts with “In the beginning,” saying the universe had a starting point. Many years later, scientists discovered the Big Bang—the moment when all matter, energy, space, and time suddenly expanded from a tiny point. It happened about 13.8 billion years ago. Both the Bible and science agree—the universe had a beginning.
Earth Hangs In Space

Back then, people imagined animals or gods holding up the Earth. Yet the book of Job in the Bible describes the Earth as one that “hangs on nothing.” Modern astronomy confirms this truth—Earth freely floats in space without any visible support.
Earth Is Round

More than 2,700 years ago, Isaiah, a Hebrew prophet, described the Earth using the term “chug” in chapter 40, verse 22, implying a circular or round form. This was long before anyone had sailed around the globe or observed Earth’s curved shadow during an eclipse. Today, satellites confirm that Earth is a sphere about 40,075 kilometers in circumference—just as described.
Stars Are Too Numerous To Count

Imagine standing on a beach and trying to count the grains of sand—it’s impossible. The Bible once compared stars to that number, which sounded like an exaggeration when only a few thousand are visible at night. However, astronomer Edwin Hubble proved it to be true that our galaxy alone has approximately 100 billion stars, with billions of galaxies beyond.
The Universe Is Expanding

In 1929, astronomer Hubble made an amazing discovery. He saw that galaxies aren’t standing still—they are all moving away. The farther a galaxy is, the faster it goes. This means the universe is growing bigger, stretching out. And long before Hubble, the Bible described God as one who “stretches out the heavens.”
The Water Cycle

Rivers continuously flow into the ocean, yet it never overflows. How can this be? The books of Ecclesiastes (1:7) and Job (36) offer early insights into the water cycle: water evaporates, forms clouds, falls as rain, and repeats the process—an accurate description confirmed by modern science.
Ocean Currents And Paths

Psalm 8:8 talks about “paths of the seas,” a mystery for thousands of years. In the 1800s, naval officer Matthew Maury studied the oceans and discovered real currents, like the Gulf Stream, which carries 150 million cubic meters of water every second. Amazingly, the Bible mentioned these ocean pathways long before anyone mapped them.
Mountains Have Deep Roots

The Bible’s Job, known for his wisdom, once described mountains as having hidden roots. Science confirms it; under mountains like the Himalayas, the ground extends deep below the surface, forming a solid foundation. These underground “roots” keep peaks tall and steady, thereby proving Job’s ancient metaphor was surprisingly accurate.
Air Has Weight And Pressure

Every time we breathe, we experience air pressure, the invisible weight of the atmosphere. At sea level, it’s about 101.3 kPa, sometimes reaching 1,086 hPa. Thousands of years ago, Job 28:25 poetically acknowledged that God “established the weight for the wind,” centuries ahead of modern science.
Earth’s Fiery Interior

In the Bible, Job spoke of ‘fire beneath’ the Earth (Job 28:5). Long ago, readers thought this was just poetic imagery. Today, science shows the Earth really has a molten core—a layer of super-hot, flowing rock that reaches about 5,400°C (9,800°F).
Blood Is Needed For Life
Science tells us that blood is essential for life; it carries oxygen and nutrients to every cell in our body. Similarly, ancient Scripture makes the same observation in Leviticus 17:11, stating, “The life of the flesh is in the blood.” Both sacred text and biological research recognize blood’s vital role in sustaining life.
Quarantine Prevents Disease Spread

Ever wonder about the word “quarantine”? It comes from the Italian quaranta, meaning forty days. This practice of isolation has proven its worth throughout history. From ancient biblical times, the book of Leviticus prescribed separating people with infectious diseases. Today, quarantine remains a scientifically proven method for controlling disease outbreaks, as seen in modern pandemic responses.
Thoughts Affect Physical Health

According to Proverbs 17:22, “A cheerful heart is good medicine, but a crushed spirit dries up the bones.” Science confirms that mental health directly impacts physical well-being. Research featured in PubMed Central highlights how mental health conditions like stress, depression, and anxiety can impair immune function, whereas maintaining positive emotions supports recovery and strengthens the body’s resilience.
Noah’s Ark Design

Modern shipbuilders know a 6:1 length-to-width ratio gives vessels the best stability at sea. Surprisingly, that’s exactly the ratio described for Noah’s Ark in Genesis 6:15. While archaeologists haven’t found direct evidence of the Ark, engineering principles suggest ancient instructions were remarkably practical for creating a stable floating vessel.
Goliath’s Height And Medical Condition

The Bible describes Goliath as “six cubits and a span”—around 9–10 feet tall. While his exact height isn’t confirmed, science shows that a condition called gigantism, caused by excess growth hormone, can make people grow to similar sizes. This makes Goliath’s description medically plausible.
Wind Can Push Back Water

Scientists have seen wind push water back in places like Lake Erie and the Nile Delta, a process called wind setdown. This natural effect echoes the Bible’s story in Exodus, where strong east winds parted the Red Sea. While the exact crossing remains unexplained, the phenomenon shows wind can indeed move water dramatically.
Cities Destroyed By Fire

The Bible tells stories of cities destroyed by fire, and archaeology sometimes finds matching evidence. At Jericho, burned layers and melted materials show that massive fires once occurred. Other cities, like Sodom, remain a mystery, and scholars debate whether meteors or other disasters caused their destruction.
The Importance Of Handwashing

In ancient times, the Bible instructed priests to wash thoroughly after contact with anything “unclean.” Centuries later, Dr. Ignaz Semmelweis proved handwashing reduces infections, confirming these rituals as early, effective infection control—long before germ theory or modern hygiene was understood.
Common Human Ancestry

According to the Bible, humanity began from a common source. Today, genetics supports this idea. Mitochondrial DNA traces all humans to one maternal ancestor, and Y-chromosome studies point to a shared paternal ancestor. These discoveries show that science and Scripture agree on our shared human origins.
Archaeological Confirmation Of Bible Places And Events

For years, many thought the Bible’s stories were only myths. Archaeology tells a different story. Excavations at cities like Nineveh and Jericho show they really existed. Other discoveries, such as Hezekiah’s Tunnel, the Pool of Siloam, and inscriptions mentioning King David and Pontius Pilate, prove some biblical events and figures were real.

